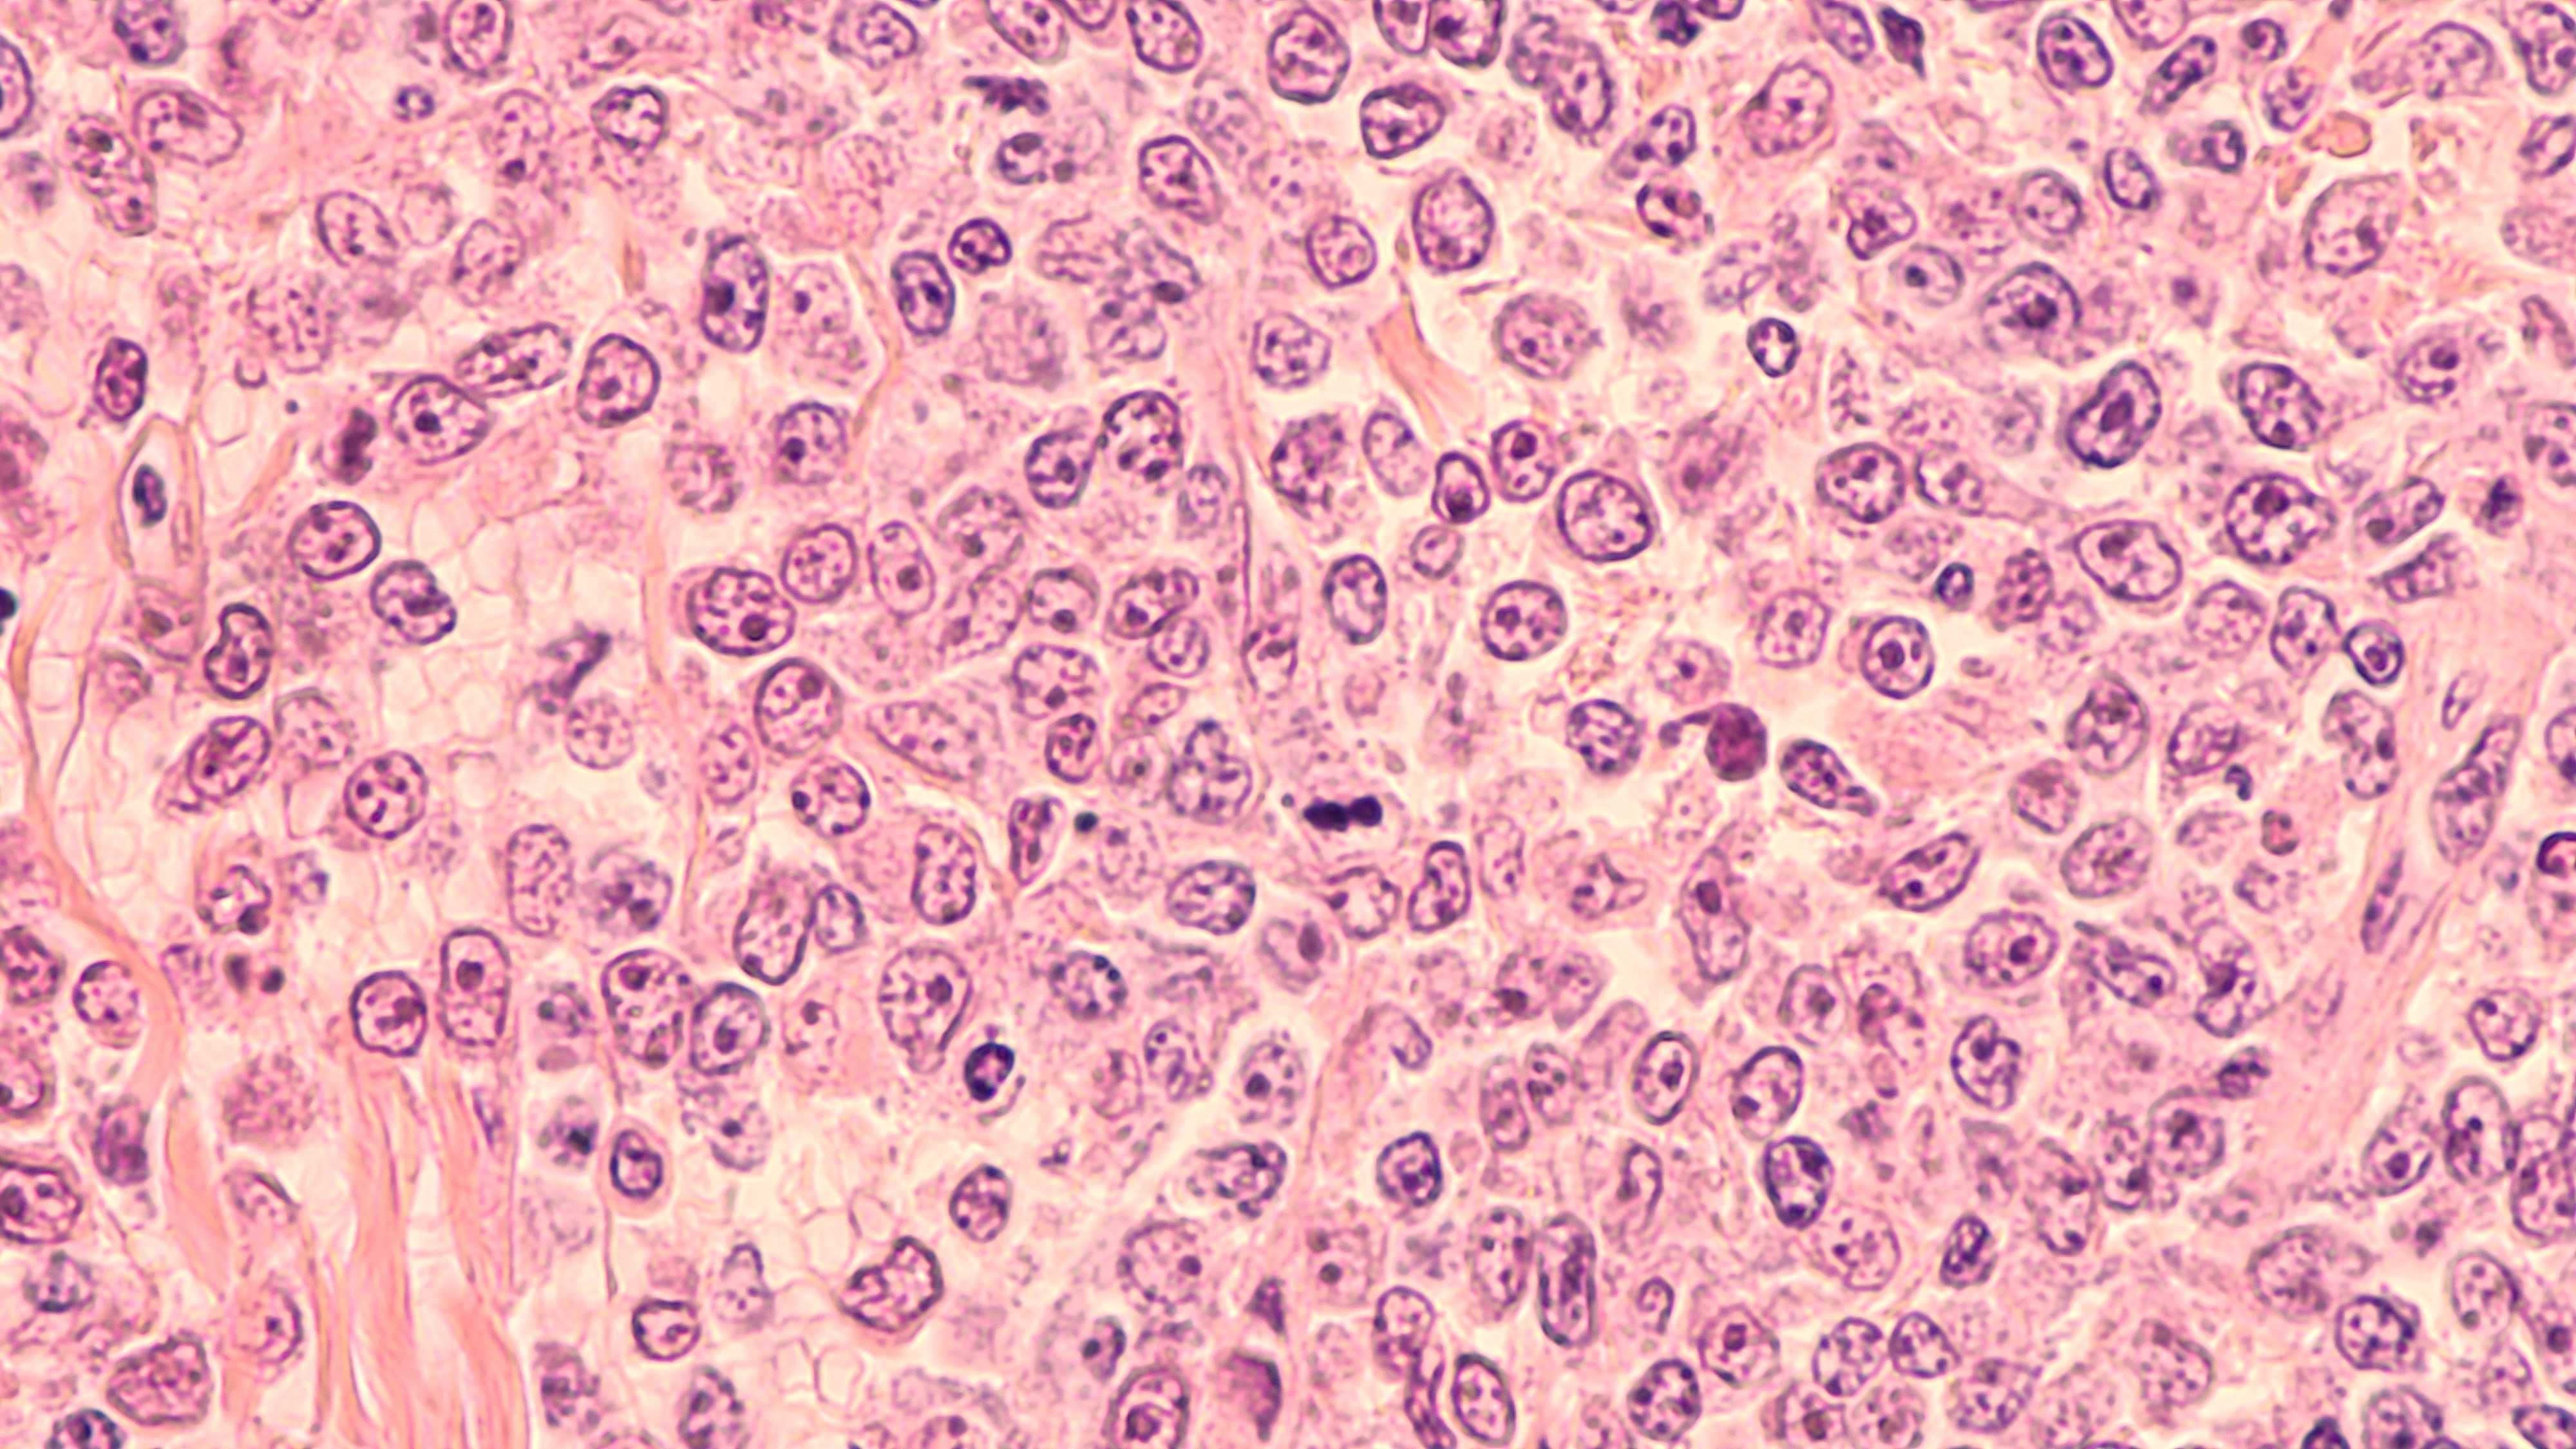
LDCBG R/R: Respuesta duradera sugerida con tafasitamab, resultados a largo plazo del estudio L-MIND

El día de ayer, 28 de septiembre, MorphoSys US Inc, dio a conocer los nuevos resultados del estudio L-MIND que mostraron que la combinación de tafasitamab + lenalidomida seguido de tafasitamab en monoterapia, brindaron una eficacia a largo plazo en pacientes con linfoma difuso de células B grandes (LDCBG) en recaída o refractario (R/R) tratados al menos durante 2 años.
Se inscribieron 80 pacientes, de los cuales 27 recibieron tratamiento al menos 2 años y tuvieron una mediana de duración del tratamiento de 4.3 años. Se observó una tasa de respuesta completa en 23 de ellos y en los 4 pacientes restantes se observó una tasa de respuesta parcial.
Los eventos adversos que se presentaron con la terapia combinada fueron neutropenia y diarrea, mismos que disminuyeron al momento de iniciar con tafasitamab en monoterapia.
Fuente:
MorphoSys Presents New Long-Term Data from L-MIND Suggesting Durable Response to Treatment with Monjuvi® (tafasitamab-cxix) for Patients with R/R DLBCL. https://www.morphosys.com/en/news/morphosys-presents-new-long-term-data-l-mind-suggesting-durable-response-treatment-monjuvir. Comunicado de prensa. Acceso el día 29 de septiembre de 2022.
Redactada por Karem Vázquez
¿No tienes una cuenta? Regístrate